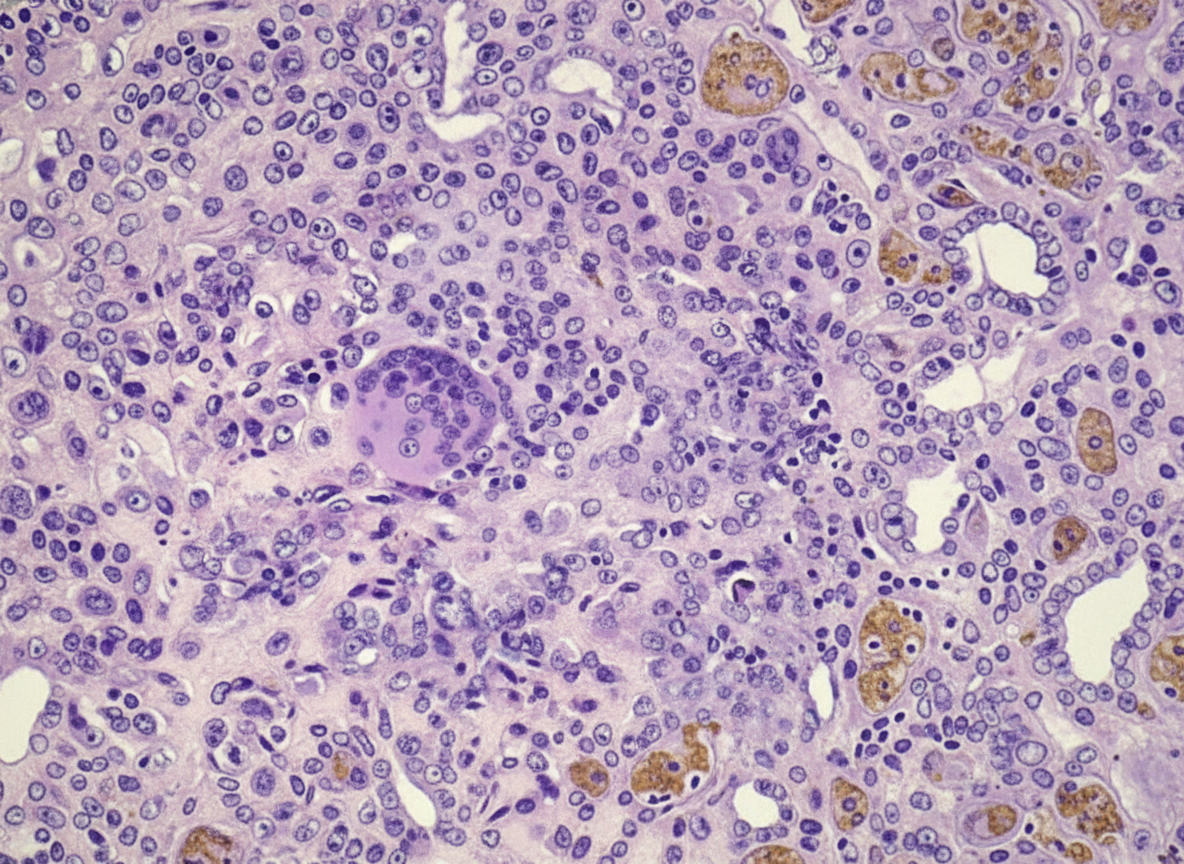
Image for question 30

A 27-year-old man develops acute pain and swelling of the left knee 5 days after an episode of urethritis. On physical examination, the left knee is swollen, warm, and tender to the touch. No other joints are affected. Laboratory examination of fluid aspirated from the left knee joint shows numerous neutrophils. A Gram stain of the fluid shows gram-negative intracellular diplococci. No crystals are seen. Which of the following infectious agents is most likely responsible for his condition?
A 60-year-old woman with arthritis suffers a massive stroke and expires. At autopsy, the proximal phalangeal joint tissue shows pannus, synovial cell hyperplasia, and lymphoid follicles. Which of the following best describes the pathogenesis of pannus formation in this patient?
In which color cap vacutainer is NaF used?
A mother delivered an infant at 38 weeks gestation without complications. Soon after delivery, she experienced respiratory distress, uncontrolled vaginal bleeding, shock, and multiorgan failure, leading to death. Autopsy revealed masses of debris and epithelial squamous cells in the pulmonary microcirculation. What was the likely cause of death?
Cervical smear fixation is done by?
Which of the following conditions cannot be diagnosed using fine needle aspiration cytology?
A 17-year-old female underwent a fine needle aspiration cytology (FNAC) for a lump in the breast which was well defined, non-tender and mobile. Which of the following pathological features suggests a diagnosis of a benign lesion?
A 20-year-old female patient presented with a thyroid swelling. Which of the following is least likely to be diagnosed by fine needle aspiration cytology?
A 50-year-old woman with long-standing rheumatoid arthritis complains of weakness and fatigue. She states that her stools have recently become black after taking a new nonsteroidal anti-inflammatory drug (NSAID). Gastroscopy shows numerous superficial, bleeding mucosal defects. Which of the following is the most likely diagnosis?
An X-ray shows a lytic lesion in the calcaneus in a young adult. Biopsy shows the following diagnosis:
Basic Principles of Cytopathology
Practice Questions
Specimen Collection and Processing
Practice Questions
Gynecologic Cytology
Practice Questions
Respiratory Tract Cytology
Practice Questions
Urinary Tract Cytology
Practice Questions
Effusion Cytology
Practice Questions
Fine Needle Aspiration Cytology
Practice Questions
Gastrointestinal Tract Cytology
Practice Questions
Ancillary Studies in Cytopathology
Practice Questions
Quality Assurance in Cytopathology
Practice Questions
Get full access to all questions, explanations, and performance tracking.
Scan to download app